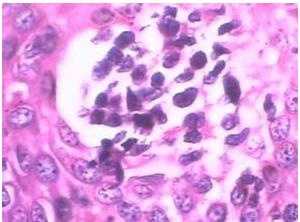
妇科里面痒怎么办,妇科痒的急救方法

对于女性来说,下面出现瘙痒是一件很尴尬,同时也让人觉得烦躁不堪的事情,尤其是在人多的公共场合,身体里简直是有几万只小虫子在爬一样,简直都想抓狂的节奏,其实这是出现了阴道炎的症状了,很多人不予以重视,导致病情越来越严重,并且反反复复迁延不愈,那么,下面咱们先了解下阴道炎的主要病因是怎么形成的?

阴道炎指的是正常健康妇女阴道由于解剖组织的特点对病原体的侵入有自然防御功能。如阴道口的闭合,阴道前后壁紧贴,阴道上皮细胞在雌激素的影响下的增生和表层细胞角化,阴道酸碱度保持平衡,使适应碱性的病原体的繁殖受到抑制,而颈管黏液呈碱性,当阴道的自然防御功能受到破坏时,病原体易于侵入,导致阴道炎症。主要的原因其实就是阴道内酸碱失衡导致的炎症反应。

临床上常见的阴道炎类型有:细菌性阴道病、念珠菌性阴道炎、滴虫性阴道炎、老年性阴道炎、*女幼**性阴道炎。
几类阴道炎常见的病因如下:
1.细菌性阴道炎,主要是由于阴道内乳杆菌减少、加德纳菌及厌氧菌等增加所致的内源性混合感染。
2.念珠菌性阴道炎,主要是多见于阴道PH值的改变所致,主要的诱因多见于妊娠、糖尿病、肥胖、大量使用免疫*制剂抑**以及广谱抗生素等。
3.滴虫性阴道炎,主要是月经前后阴道内环境的改变,常与其他的阴道炎同时出现。
4.老年性阴道炎,因为绝经后妇女的卵巢功能衰退,雌激素水平降低,阴道壁萎缩,黏膜变薄,阴道内pH增高,局部抵抗力降低,其他致病菌过度繁殖或容易入侵引起炎症,以需氧菌为主。
5.*女幼**性阴道炎
因婴幼儿外阴发育差、雌激素水平低及阴道内异物等造成激发感染所致,常见病原体有大肠埃希菌及葡萄球菌、链球菌等。
注意以下的4点,防止阴道炎出现:
1、慎用阴道冲洗,虽然说阴道冲洗可以使其阴道内部清洁,去除残留的白带,消除阴道内的病菌,但是频繁的阴道冲洗是会影响阴道内的酸碱平衡,因为洗剂本身大多都是碱性的,所以会破坏阴道内的乳酸杆菌,反而引起妇科问题,所以说,不要自我觉得为了卫生就反复冲洗,其实这才是最不卫生的。

2、广谱抗生素,抗生素一般都是由于消炎、抗菌等治疗,并且说长时间的使用会有一定的依赖性,并且还会引起一定的内环境改变,引起酸碱失衡。

3、不洁的夫妻生活,在夫妻之间进行*生活性**的时候,可能由于不清洁的原因将病菌带入,也是可以导致阴道炎症,也是很常见的一个诱因,所以,在那个的时候一定要注意前后的卫生清洁。

4、长期久坐,因为长期的坐姿会使*体下**潮湿、闷热,而病菌就喜欢在潮湿的场所生存、滋生,尤其是女性在经期的时候,免疫力最差,很容易被感染,所以即使是经期也要注意卫生哦!
